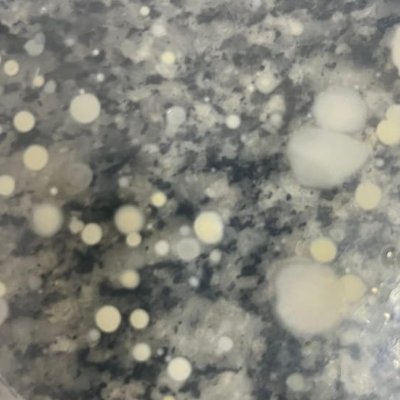

luv 💤 @dr4ckner
Artist / Producer 🇧🇷 instagram.com/dr4ckner/ Praga, República Checa Joined October 2018-
Tweets19K
-
Followers52
-
Following292
-
Likes55K
Uma vez eu amei tanto uma flor que ao invés de arrancá-la, eu a deixei em paz.
Xaiversobased & Nettspend - shine n peace (2023)
Tenho me sentido assim
eu tirei isso de mim mesmo. o problema sou eu
eu tirei isso de mim mesmo. o problema sou eu
minha amg gravou o tchovis e o mêbous com togles caindo na scrabgadun na saída do show do wingslompson
minha amg gravou o tchovis e o mêbous com togles caindo na scrabgadun na saída do show do wingslompson
essa musica eh uma reflexao de cogumelo
Um nome? mimi Aparência? Franjudinha Um meme? Amo comer bosta e tomar mijo Personalidade? Borderlinda esquizofofa Uma banda? Deftones Uma cantora? Lana del rey O que eu amo? Hello Kitty Meu sonho? Matar todas as meninas q meu namorado já conversou
Um nome? mimi Aparência? Franjudinha Um meme? Amo comer bosta e tomar mijo Personalidade? Borderlinda esquizofofa Uma banda? Deftones Uma cantora? Lana del rey O que eu amo? Hello Kitty Meu sonho? Matar todas as meninas q meu namorado já conversou
se vaza mensagem da minha mulher falando que eu não consigo fazer ela gozar eu ia Kurt Cobainar minha cabeça fora snrz
se vaza mensagem da minha mulher falando que eu não consigo fazer ela gozar eu ia Kurt Cobainar minha cabeça fora snrz
meus vícios sendo amar de amar + respeitar o próximo + fazer o bem sem olhar a quem + compreender até o demonio + nicotina
meus vícios sendo amar de amar + respeitar o próximo + fazer o bem sem olhar a quem + compreender até o demonio + nicotina https://t.co/5yI0ER5T6z
a resenha não para

ge @gehleca
3 Followers 7 Following fall in. fall in love. fall in love again. fall in love again and again.
xander @whosalex
54K Followers 47K Following
gu @Gustavo96382840
4 Followers 8 Following
˙. ꒷⋆ Melancolis... @Sigaho_
329 Followers 313 Following
Rurthetue @RurthetueFg0cH
6 Followers 360 Following
Kiki Deliciosa @sodadekkkkjj
4 Followers 62 Following
SussKay @blondedperson
30 Followers 244 Following Você merece todo o amor que tenta dar aos outros. Insta: @kkay_ocean Curto Frank Ocean e ouvir uns Lofizinho. Bhop é dahora.
. @pedutti_
28 Followers 138 Following
dimi ( 2 conta ) @_dimitrisanders
7K Followers 1K Following conta secundária / principal @dimitrisanders_
gbc 🖤 @gothboycIick
6K Followers 7K Following
nic @alucinacaoly
2K Followers 2K Following
tinny ☽⋆. @myoonluvs
883 Followers 934 Following .☆𝑆𝑎𝑢𝑑𝑎𝑑𝑒. a tristeza da ausência, mas a felicidade pela memória do que vivemos juntos.
lucas @2007underdog
30 Followers 341 Following
Do Better ✘ @gymbestworkouts
46K Followers 32K Following If you would like to be a brand ambassador for @theimpacktbrand please email [email protected]
lari @ri_lka
39 Followers 53 Following Você é perfeito, porque você não existe. (Não você). (Nunca você). ~𝑨 𝒗𝒊𝒅𝒂 𝒊𝒏𝒗𝒊𝒔𝒊𝒗𝒆𝒍 𝒅𝒆 𝑨𝒅𝒅𝒊𝒆 𝑳𝒂𝑹𝒖𝒆
. @bedroomtrinkets
74 Followers 488 Following
emys @loveslittlejjk
894 Followers 888 Following When this song ends, may a new song begin. ً ︎︎︎︎︎︎︎︎︎︎︎︎︎︎︎︎︎︎ ︎︎︎︎︎︎ ً Hoping that, I'll be a little happier.
DJ neurodivertido @diversaoezap
270 Followers 838 Following Kethelen Raueny e Phillype Marcus mamãe ama vocês 👩👧👦 05/03/2019 eterno perninha do morro✝️🖤 Filha do Deus vivo🙏🙌 Esposa do @ramonreliquiaddd21 💍
Rafael @Rafael_magalh_
4 Followers 319 Following
Bru 🐈⬛ @brunagilio_
48 Followers 153 Following
Fernanda🎀 @nandanessamerda
108 Followers 502 Following
PADRIM @fbctadoido
200K Followers 28K Following Pai, MC, Aquarista meia boca. Enxadrista de praça. Um cria do viaduto Santa Teresa. Gosto de ouvir música. Embaixador @bebaxequemate @kennerofc
ge @gehleca
3 Followers 7 Following fall in. fall in love. fall in love again. fall in love again and again.
lonely @destroylonely
434K Followers 29 Following
wplace @wplacelive
44K Followers 3 Following Official account for Wplace, a massive live pixel art canvas layered over the world map. Made in Brazil 🇧🇷
guizin Ohh +Brabo!! @guizin_botson
29K Followers 1 Following 🤖 Bot que relembra tuítes do guizin_jeferson. Alguns que mencionam datas são adaptados.
gu @Gustavo96382840
4 Followers 8 Following
madmoser @gtmadss
2K Followers 1 Following
. @playboicarti
2.9M Followers 0 Following
໊ @IAMMUSIC
64K Followers 211 Following
˙. ꒷⋆ Melancolis... @Sigaho_
329 Followers 313 Following
Cris e Marcio Vida At... @crisrisoleu
153 Followers 78 Following Uma família atípica, lidando com o Autismo na infância e na adolescência. Dos nossos 3 filhos, 2 tem autismo 🧩🧩💙💙
FERNANDO GIL RN @flamiliagil
48K Followers 1K Following Comentarista do canal Fernando Gil RN : https://t.co/X6zxssKiCr Pai e filha doidos pelo Mengão. Instagram: fernandogilgil
Thisgao 🇵🇸 @Sxnthiagv
296 Followers 2K Following Quem não pode errar sou eu. Engenheiro em formação 🦈 🎣 @ipreferjuice 🥰🌻
ye @kanyewest
33.0M Followers 1 Following
The Mac Miller Memoir @MacMillerMemoir
193K Followers 14 Following In loving memory of Malcolm James McCormick.
NBA da bad @NBAdabad
369K Followers 763 Following 🏀 Cobrindo basquete sempre com muito humor 📧 Parcerias: [email protected]
فرناندا �... @doutorfaggot
4K Followers 277 Following as above so below, as within so without, as the universe, so the soul | esposa : @linkdozap 💌
Raiam Santos McArn @raiam700
268K Followers 1K Following Viajei pra 104 países, formei na mesma faculdade que o Elon Musk, escrevi 11 livros e joguei na Seleção 🇧🇷
daniel crash bamdicot... @danielpassapicc
37K Followers 715 Following aspirante a biologo nas horas vaga𓆏𓆉 parcerias📧: [email protected]
acervo claire cottril... @acervoclairo
8K Followers 741 Following sua melhor fonte de memes e estáticos da cantora e compositora grammy nominee claire cottrill 🤍